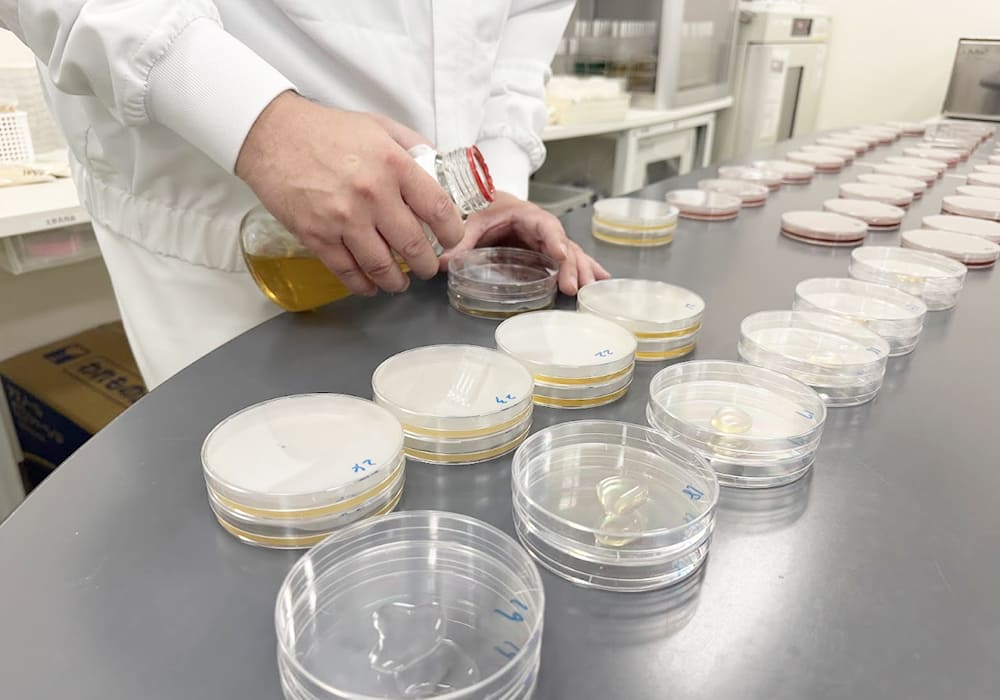

私たちは、オニオン・ガーリック・香辛料の乾燥およびパウダー加工を専門に行う食品素材メーカーです。この分野に特化した企業は全国的にも数が少なく、当社はオニオン・ガーリック・スパイスにおける専門メーカーとして、国内有数の実績を誇っています。一般消費者の方にとってはあまり馴染みがないかもしれませんが、当社の製品は、カレールーやインスタントラーメン、スナック菓子、焼き肉のたれ、ドレッシング、タルタルソースなど、皆さんの食卓に並ぶ数多くの有名食品に使用されています。きっと一度は、私たちの素材が使われた商品を口にされたことがあるはずです。目立たないながらも、”おいしさの裏方”として、食品業界を支えるやりがいのある仕事に取り組んでいます。

吉田商事株式会社
よしだしょうじかぶしきかいしゃ
- 製造業
- 南あわじ市
- 食堂あり社宅・社員寮あり職場見学OK奨学金返済支援制度導入企業WLB認定企業or宣言企業資格取得支援制度ありジョブローテーションあり研修制度あり産休・育休あり時短勤務制度あり教育制度あり平均残業時間が月20時間以内制服支給あり島外転勤なし高卒採用あり高年齢者雇用あり代表者が40代商品開発体を動かすのが好き手に職をつける接客企画力が活かせる事務語学力が活かせるエンジニアものづくりみんなでわいわい作業ができる企業サイト・採用サイトあり企業SNSありシェアNo.1や特化した技術・サービスを持っているBtoB
会社のこと、ねほりはほりインタビュー
その味の裏側に、私たちがいます。実はあなたも食べているかも?
食品業界を支える縁の下の力持ち。
代表取締役社長吉田 圭吾 まず御社について伺います。どんな製品を作っている会社でしょうか? 高校生や大学生にも分かるように、できれば具体例つきで教えてください。
私たちは、淡路島で主に淡路島玉ねぎと国内特産野菜の乾燥をして紛末や顆粒に加工しています。いわゆる食品加工業で、原料となる乾燥チップを海外からも仕入れ、粉砕・調合して、“味の土台”になる素材をつくる会社です。

“味の土台”という表現が印象的です。粉末はどんな食品で活躍しているのですか? 想像しやすいところから教えてください。
意外に思われるかもしれませんが、カップ麺のスープの原材料にも私たちのオニオンやガーリックの粉末が入っていることがよくあります。
えっ、カップ麺のスープにも!
原料としてよくご使用いただいているのは、スナック菓子の味付け、焼き肉のたれやドレッシング・お鍋の素等の各種の調味料です。家庭用だけでなく業務用も多いですね。さらにレトルト食品、たとえばレトルトカレーやスープ、ソースのベースにも広く使われています。

それは日常の“ど真ん中”ですね。自分の仕事が全国のコンビニやスーパーの棚に並ぶイメージ、ワクワクします。
そうなんです。しかも間に商社さんが入ることも多く、納入先の最終ブランド名をこちらが把握しないケースもあります。あとから『実はあの商品に入っていたよ』と聞いて、『あ、そうなんや!』と驚くのは社員にとって嬉しい瞬間です。
なるほど、縁の下の力持ちという感じが伝わってきます。社内の体制についても教えてください。部署の数や、だいたい何人くらいで回しているのですか?
部署は5つです。総務部、品質保証部、技術室、生産管理部、製造部。全体でおよそ60名が働いていて、そのうち製造部だけで40名ほど。正社員に加えて派遣やパートの方も在籍しています。
製造部だけで半分近い規模なんですね。年齢層や採用の方針はどうでしょう。若手として入るイメージを持ちたい就活生が多いと思うので、その視点で教えてください。
年齢層の平均は46歳前後で、歴史のある会社らしくベテランが多いのは事実です。
一方で、私たちの本音としては新卒・中途にこだわらず若い力を積極的に採用したいと考えています。現状は中途比率が高いのですが、世代交代と技術伝承の両立を意識して採用強化を進めています。

若手ウェルカムは心強いです。離職率の状況や、働きやすさのために制度面で変えたことがあれば教えてください!
離職率は以前より下がってきています。背景には就業規則や各種規程の見直しがあり、現場の実情に合わせて“働きやすさ”を地道に整えてきたことが大きいと思います。たとえば休憩やシフトの取り方、手当のルールの明確化など、細かいけれど現場に効く改善を重ねています。
現場に効く改善は信頼感につながりますよね。実際の働き方も気になります。勤務時間や残業、休日はどんなイメージでしょうか。
基本の勤務は8時から17時です。定時を大事にする意識が根づいていて、残業はあっても30分程度というのが今の感覚です。休日は日曜・祝日がお休み、土曜は月1〜2回の出勤です。しっかり休む前提で計画を立てる文化です。
“定時で帰る前提”は大きな安心材料ですね。品質や衛生管理の考え方も聞かせてください。食品だとそこが最重要だと思うので。
当然ながら衛生意識は全員に徹底しています。入室手順、手洗い、異物混入防止、記録の管理など、基本動作を確実にやることが品質の第一歩です。品質保証部が運用をリードしつつ、各部署が自分ごととして取り組む体制です。

ありがとうございます。では、実際の製造現場の仕事をもう少し具体的に。どんな設備を使って、どう粉末にしていくのでしょう?
例を挙げると、ボールミルという粉砕機を使います。乾燥させた玉ねぎのチップを上部の投入口から投入すると、内部の多数のボールが回転して衝撃と摩砕で細かい粉末にしていきます。粒度や風味のコントロールが重要で、粉砕条件やブレンド比率を調整しながら狙いの品質に近づけます
工場の映画で見るような大きな機械ですね。安全対策はどうしていますか? 高所作業や重量物もありそうです。
原料は一袋20〜30キロと重いので、人力で運ぶ代わりに、フォークリフト運搬用のパレットという荷台にきちんと積み、ストレッチフィルム(レンジでチンする際に使うラップの大型のもの)で固定します。
フォークリフトで中二階の投入位置まで上げ、設置後は昇降式の手すりを必ず起こして転落を防止します。投入時は手順書に沿って声出し確認を行い、装置停止の安全確認をしてから作業に入るのがルールです。
具体的な手順まで明確ですね。フォークリフトは免許が必要ですが、その取得支援はありますか?
はい。フォークリフトはもちろん、玉掛け技能講習、そして国家資格の衛生管理者など、業務に関わる資格は会社が取得費用を全額補助します。現場配属のタイミングや業務内容に合わせて、必要な順に計画的に取ってもらいます。
“全額補助”は強い。お金の心配なくスキルを積めるのは、初めての就職には大きな後押しです。製造だけでなく、開発寄りの仕事もあるのでしょうか?
あります。お客様と一緒に商品設計を詰める案件では、技術室が中心となり風味の方向性、焙煎(ロースト)の度合い、粒度、濃度などの条件を合わせていきます。サンプルを10回、20回とやり取りすることも珍しくなく、開発に3ヶ月から半年かけるケースもあります。
地道ですが、狙い通りの味が決まったときの達成感は大きいですね。

味の“設計”をする仕事、めちゃくちゃ面白いです。やりがいの源泉は、やっぱり世に出る瞬間でしょうか。
その通りです。自分たちの粉末が人気商品に採用されたと知ったときは、本当に嬉しい。社内でも『買ってみよう』と盛り上がって、実際に食べて確かめることもあります。『この香り、うちのだよね』と共有できるのは最高です。
逆に、しんどいところや課題も正直に教えてください。就活生にはリアルな情報がいちばん役立ちますから。
重量物の取り扱いなど体力を要する場面はどうしてもありますし、すべての工程がフルデジタル化されているわけではありません。紙のチェックシートや目視確認など、アナログな作業も残っています。
ただ、だからこそ一つひとつの業務を見直して小さな効率化を積み重ねる余地があるとも言えます。最近は投入補助具の導入、帳票の電子化、段取り替え手順の標準化などを順次進めており、負荷は確実に下がってきています。
改善が進む現場は、入社後に貢献できる余地が大きいのが魅力ですね。ところで、休日や残業の運用は実態と制度がズレることもありがちですが、その点はいかがでしょう。
『休むべきときは休む』を前提に計画します。生産の都合で増員や応援を組むことはあっても、個人の無理な長時間残業で帳尻を合わせるやり方は取りません。生産管理部が需給を見ながら計画し、製造部と密に調整しています。
現場任せにせず、組織として支える設計なんですね。働く人の居住地は淡路島が中心ですか?
島内の方に加え、徳島や神戸(三宮あたり)から通う社員もいます。通勤圏は思ったより広いですよ。

ありがとうございます。ここまでで会社の全体像がかなり見えました。では、就活生へのメッセージとして“どんな人に向いているか”をズバリ教えてください。
決まった手順をきちんと守ることが好き、あるいは得意な人は向いています。食品は衛生・品質が命ですから、基本を丁寧に積み重ねられる人が力を発揮できます。また、自分の中に『ここは大事にしたい』という軸を持っている人。待遇や仕事内容などすべてが百点満点の職場はなかなかありませんが、軸が守られていれば納得して働ける。そういう価値観を大事にできる人と一緒に働きたいです。
まさに“誇れる地味さ”。最後に、会社としてのアピールをお願いします。この記事の締めにふさわしい言葉で、高校生や大学生に直接届けたいです。
私たちの仕事は派手ではありません。けれど、毎日の“おいしい”を支える確かな基盤です。淡路島から日本中の食卓へ、安心と品質を乗せて原料を届ける。それが私たちの使命であり誇りです。
若い皆さんには、ここで学べる技術と姿勢がきっと将来の大きな力になります。資格取得は会社が全額支援しますし、定時を大切にする文化の中で無理なく成長できます。『食に関わる仕事がしたい』『社会の役に立っている実感がほしい』そんな思いが少しでもあるなら、ぜひ一度、私たちの工場を見に来てください。
あなたの手でつくった一粒の粉が、明日の“おいしい”を支えます。ぜひ私たちの仲間になってください。
ホンネで教えて、社員さん!
製造課佐川さんに
一問一答
-
会社の好きなところはどこ? -
定時に仕事を終わらせようという意識が根付いているところです。 -
入社前後で変わったところ(会社の印象)は? -
上司や先輩方の雰囲気が温かく、相談や質問がしやすいところです。 -
仕事のおもしろさって? -
生産の各工程など、慣れや自分の工夫で上達したり、効率が良くなっていくのを実感できること。 -
今後挑戦したいことは? -
これまで携わった以外の工程や、生産予定の段取り等。 -
どうして淡路島の会社を選んだの? -
実際のところ決め手となったのは場所ではなく働きやすさ。「淡路島で働きたいから」という理由ではありません。 -
淡路島で大好きな場所はある? -
業務スーパー(近いので) -
プライベートの過ごし方は? -
推し活に係るイベントや、音楽団体に所属しているので合奏練習などでよく島外へ出かけます。
あとは平日は家にいて、休日は個人練習、掃除などで終わっていきます・・・ -
求職者へ一言! -
自分のやりたいことや適性、求めるものをよく理解することが重要と考えます。
わが社のシーン集めました
-
マネジメントレビューを年2回開催 -
パウダーの粒度検査中 -
社長とコミュニケーション -
お客様へのサンプル作成中 -
企業説明会に参加 -
ノベルティのポストイット -
使いやすい小容量製品に小分け中 -
原料投入! -
避難訓練時の消火訓練のようす
会社早わかりデータ
-
誇れる数字
11.58日
「しっかり働き、しっかり休む」ことを大切にしています。私たちの会社では、有給休暇の取得をしっかり後押ししています。国の義務である年5日を上回る6日以上の取得を社内ルールとし、一部の部署では7日取得を推奨するなど、積極的な制度づくりを進めてきました。「頑張ってくれている社員に、しっかり休んでほしい」そんな想いから始まった取り組みです。実際に、社員の平均有給取得日数は11.58日と、全国平均を上回る実績があります。また、有給の申請は業務に支障がない限り基本的に断ることはありません。勤務時間も、拘束時間9時間・実働7時間20分と短めで、プライベートとの両立がしやすい環境です。「仕事も、暮らしも、どちらも大切にしたい」そんな方にぴったりの職場です。 -
会社を動物で表すと
どっしりゾウ
会社を動物で表すと私たちは、象のようにどっしりと、安定感のある会社です。当社は、大手食品メーカー様や流通企業様からのご依頼を受けて製品を製造する「委託加工」を中心に事業を展開しています。原料はお客様から支給いただき、当社で全量を加工。そのすべてをお客様が引き取ってくださるため、売れ残りのリスクや不良在庫を抱える心配がありません。さらに、大手企業様との継続的なお取引により、未払いなどのリスクもほとんどなく、経営はとても安定しています。原料仕入れの負担がない分、製造に集中できる。それが、私たちの強みです。将来を見据えて長く働きたい方にも、安心して選んでいただける環境が整っています。 -
従業員数
60人
-
平均勤続年数
10.3年
-
男女比
- 男性
- 77%
- 女性
- 23%
-
会社の自慢
うちの会社は淡路島で1番
スパイスで毎日を彩る
会社です私たちは、“スパイスで毎日を彩る”会社です。淡路島で、オニオン・ガーリック・香辛料を乾燥・パウダー化することに特化した、日本でも数少ないスパイスの専門メーカーです。シナモンの甘い香りに包まれる日もあれば、ピリッと刺激的なコショウの日も。そして多くの日は、オニオンとガーリックが工場中をスパイシーに盛り上げてくれます。そんな“香りと味のプロフェッショナル”が、あなたの食卓の裏側を支えています。 -
おもしろ制度・取り組み
ゼロから、未来の“頭脳”を育てています。当社ではOJT(現場教育)に力を入れており、品質保証部をはじめ、全社的に“育てる風土”が根付いています。品質保証部は、FSSC22000の認証を受けた当社におけるシンクタンク的存在。にもかかわらず、理系出身の新卒や異業種からの転職者など、未経験からのスタートも多く、検査や品質に関する専門知識を一から丁寧に指導しています。この育成の姿勢は、品質保証部に限らず他部署でも同様で、将来の幹部候補として、未経験者を積極的に迎え入れています。また、OJTに加えてマナー講座や資格取得支援などの外部研修にも積極的に取り組んでおり、第一種衛生管理者や食品表示診断士などの資格取得実績もあります。「経験よりも、意欲と成長力」。それが、私たちが人材に求める一番の資質です。 -
今後の野望
「淡路島のタマネギを、もっと安心・もっとおいしく。」当社では、グループ会社が淡路島産のタマネギを仕入れ、皮むき・スライス・乾燥・殺菌を行った後、当社工場にて粉砕・選別・充填を行っています。このように、工程ごとに専門性を活かしながら、品質と安全性の高い製品づくりに取り組んでいます。そして、皆さまに支えられ、当社は創業60周年を迎えることができました。次の節目となる100周年に向けて、私たちはタマネギの農業生産そのものにも挑戦しようとしています。それは、お客様・消費者の皆さまに、「本当に安全で、根拠のある安心」をお届けするため。タマネギという素材を、生鮮野菜から一貫して自社で育て、加工し、製品にする。そんな“見えるものづくり”を、これからも追求してまいります。
代表者ってこんな人
失敗しても良い。大切なのは、その後どう成長するかです。
代表取締役社長吉田 圭吾
誕生日 1983年05月17日 血液型 A型 出身高校/
部活神戸国際大学付属高等学校/
ゴルフ出身大学 大阪商業大学 趣味 美味しい物を食べること 宝物 家族 好きな映画 ジブリ映画 座右の銘・
好きな言葉失敗は成功のもと 若手職員のからのメッセージ
-
会社の好きなところは?
定時に仕事を終わらせようという意識が根付いているところ。
上司や先輩方の雰囲気が温かく、相談や質問がしやすいところ。製造課 男性
会社概要
所在地 〒656-0451 兵庫県南あわじ市神代社家839 代表電話番号 0799-42-1740 創業・創立 1965年 資本金 4,000万円 売上高 2024年6月期29億6,000万円
2023年6月期27億7,000万円勤務条件
給与 - 院卒:23.0万円
- 大卒:20.3万円
- 短大卒:19.0万円
- 専門卒:19.0万円
- 高卒:18.5万円
昇給 年一回 但し、会社業績及び人事評価により決定 賞与 3.0カ月 但し、会社業績及び人事評価により決定 諸手当 交通費・役職手当・資格手当
勤務地 兵庫県南あわじ市神代社家839 勤務時間 8:00~17:00(実働7時間20分) 休暇 - 年間休日:111日:年末年始・GW・お盆あり:会社カレンダーによる
- 休日:特別休暇(慶弔・資格取得)産休・育休等、労働法が定める休日
- 有給休暇:6か月の継続勤務後10日付与
- 時間有給2日分16時間あり
福利厚生 移住補助・遠隔地交通費補助・奨学金返済補助
免許 普通第一種免許(部署によりAT限定可) 定年 60歳まで(再雇用制度有 65歳まで) 採用情報
担当課名 総務部 直通電話番号 0799-42-1740 メールアドレス info@yoshida-shouji.co.jp 入社後の流れ 入社時研修:FSSC22000認証企業の社員として、遵守しなければならない事項の研修
↓
社内研修:全社的な業務の流れに関する研修
↓
配属部署研修:配属部署での最初の研修 -

さらに、淡路島の自然の中で、残業少なめ・資格は全額補助・仲間との距離が近いという環境で、安心して働ける職場でもあります。
全国各地で販売される商品に自分の仕事がつながる、そんな大きなやりがいを求める人に向いている職場なのではないでしょうか。